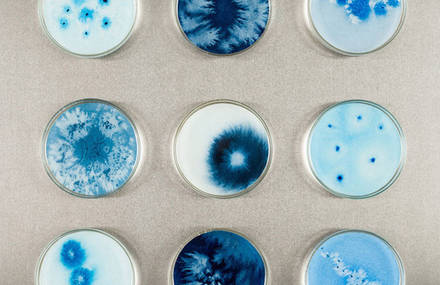

En Iwamura est un artiste-sculpteur né à Kyoto, spécialisé dans la céramique....
58
Custom your daily dose of inspiration
Access to exclusive content and new products before everyone else
Add to favorites your articles on Fubiz
En Iwamura est un artiste-sculpteur né à Kyoto, spécialisé dans la céramique....
58